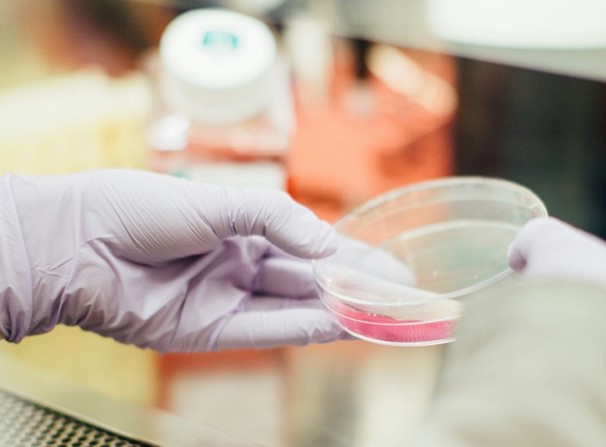

Az állattenyésztési élelmiszerláncban tevékenykedő, hasonló gondolkodású uniós partnerekből álló „Európai Állattenyésztés Hangja” elnevezésű csoport újabb kommunikációs anyagában a „sejtalapú hússal” kapcsolatos tények és állítások közötti jelenlegi szakadékokra, eltérésekre hívja fel a figyelmet.
„Sejtalapú mezőgazdaság": a „sejtalapú hússal” kapcsolatos tények és állítások közötti jelenlegi szakadékok.
Egy 2019-es RethinkX jelentés azt jósolta, hogy az Egyesült Államok hús- és tejipara 2030-ra csődbe megy a „sejtalapú mezőgazdaság” megjelenése miatt. Ez nyilvánvalóan nem következik be, mivel még mindig jelentős technikai kihívások akadályozzák ezen technológia kereskedelmi életképességét. A befektetett milliárdok és a területen működő több száz start-up cég ellenére a sejtalapú mezőgazdasági termelés olyan akadályokkal kénytelen szembesülni, mint a magas termelési költségek és a szabályozási problémák (például a géntechnológiával módosított szervezetekre vonatkozó európai szabályozási kérdések következtében).
Fotó: ELV - What role for lab-grown meat?
A termékek előállításának költségessége, különösen a precíziós fermentáció esetében, továbbra is jelentős akadályt jelent. (Megjegyzés: Precíziós fermentációs eljárás során géntechnológiával módosított mikroorganizmusokat (élesztőgombákat, gombákat, baktériumokat, algákat) használnak fel különféle anyagok, például fehérjék előállítására.) A sejtalapú fehérje-előállítás ma még mindig nem valósítható meg gazdaságosan, mivel a technológia terén további fejlesztésekre van szükség, első sorban a bioreaktorokban történő előállítás technológiája, valamint a tenyésztőközegek, táptalajok terén. Jelenleg csak egy laboratóriumban előállított, in vitro élelmiszertermék van hivatalosan bejegyezve Szingapúrban. Megalapozott gyártási protokollok nélkül a sejtalapú termékek táplálkozási és környezeti előnyeire vonatkozó állítások nem igazolhatóak, ellenőrizhetőek. Ezen felül a „sejtalapú hús” jogilag nem minősül „húsnak” az amerikai és az európai definíciók szerint, mivel az nem felel meg a hagyományos tápanyag-összetételnek és minőségnek.
Elmondható továbbá, hogy a sejtalapú mezőgazdasági rendszerből hiányoznak a hagyományos állattenyésztési rendszerek által biztosított ökoszisztéma szolgáltatások és azok minden előnye is. A multinacionális vállalatok által ellenőrzött luxusélelmiszerek létrehozásával a sejtalapú mezőgazdasági termék-előállítás pedig tovább súlyosbíthatja a globális egyenlőtlenséget. Emellett ezen termékek esetében a fogyasztói elfogadottságot gyakran túlbecsülik, bár sokan hajlandóak kipróbálni a sejtalapú termékeket, de nem fogyasztják azokat rendszeresen. A vidéken élő fogyasztók pedig különösen a természetellenesség és a hagyományos gazdálkodásra gyakorolt hatások miatt fejezik ki aggodalmukat.
Mivel a sejtalapú termékek hosszú távú egészségügyi, biztonságossági, környezeti és piaci hatásai még mindig nem tisztázottak, a sejtalapú mezőgazdasági technológia nem tűnik működőképes lehetőségnek a belátható jövőben.
Javasoljuk, hogy olvassák el a témában az Animal Frontiers lapban megjelent, Paul Wood, Lieven Thorrez, Jean-François Hocquette, Declan Troy, Mohammed Gagaoua szerzőktől származó, angol nyelvű, “Cellular agriculture”: current gaps between facts and claims regarding “cell-based meat” című dokumentációt.
Forrás: ELV - What role for lab-grown meat?
![]()
NAK/Borovka Zsuzsa

















